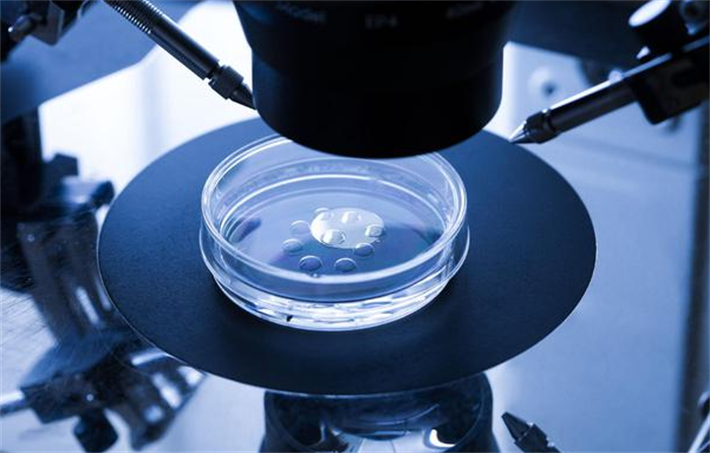
一代试管技术

试管婴儿技术,即体外受精-胚胎移植(IVF-ET)技术,经过多年的发展,已经衍生出了三代不同的技术,每一代技术都有其独特的原理:
一代试管婴儿(IVF-ET):让卵子和精子在培养皿中自然结合。然后,将发育到一定阶段的胚胎移植到女方的子宫内,等待着床妊娠。

二代试管婴儿(ICSI):通过单精子卵胞浆内注射技术,直接将单个精子注射到卵子内,实现精准受精。不过,由于是人工干预受精过程,跳过了自然受精过程中精子的自然筛选,所以存在一定的风险,如会增加胚胎染色体异常的风险,进而对后代的健康产生潜在影响。

三代试管婴儿(PGT):能在胚胎移植前进行染色体筛查和基因诊断。它通过对胚胎的染色体和基因进行检测,筛选出没有遗传缺陷的胚胎进行移植。
如何依据自身情况选对IVF技术?

锦欣国际(梦美生命)美国HRC-Fertility生殖医疗中心专家表示,选择IVF技术时,生育需求者需要综合考虑多个因素,如不孕原因、遗传风险、年龄因素等,只有这样,才能选对适合自己的IVF技术,提高试管婴儿的成功率。
1、根据不孕原因选择

不孕原因是选择IVF技术的重要依据。如果是女性因素导致的不孕,如输卵管阻塞、排卵障碍等,可选一代试管婴儿技术。而对于男性因素导致的不育,如严重少弱畸精症、梗阻性无精症等,二代试管婴儿技术则更为合适。
2、评估遗传风险

如果夫妻双方有家族遗传病史,如地中海贫血、血友病、囊性纤维化等单基因遗传病,或者染色体异常,如平衡易位、罗氏易位等,建议使用第三代试管婴儿技术进行胚胎植入前遗传学诊断或筛查。因为这些遗传疾病可能会通过自然生育传给后代,给孩子的健康带来严重影响。通过第三代试管婴儿技术,专家可以在胚胎阶段识别并避免移植带有致病基因的胚胎,极大降低孩子患病风险。
3、考量年龄因素

年龄是影响试管婴儿成功率的重要因素之一,尤其是女性年龄。随着女性年龄的增长,卵子质量逐渐下降,染色体异常的风险也显著增加。因此,35岁以上的女性可优先选择第三代试管婴儿技术进行胚胎染色体筛查,筛选出染色体正常的胚胎进行移植,以降低流产风险。
成功案例分享:选对IVF技术后的好孕逆袭
HRC案例一:染色体异常下的三代技术曙光

艾丽(化名)和丈夫结婚多年,一直渴望拥有一个孩子。然而,她在38岁时经历了两次自然流产,之后尝试试管婴儿技术,又连续两次失败。来到HRC后,专家对他们进行了染色体检查,结果发现艾丽的染色体存在平衡易位。自己为他们详细介绍了第三代试管婴儿技术后,他们决定尝试。HRC专家也筛选出了染色体正常的胚胎进行移植,使艾丽成功怀孕,并顺利生下了一个健康的宝宝。回想起那段艰难的求子路,艾丽感慨万分:“如果没有第三代试管婴儿技术,我们可能永远都无法拥有自己的孩子。”
HRC案例二:男性不育的二代技术突破

汤先生患有严重少弱畸精症,精子数量少且活力低。他们尝试过自然受孕,也做过多次人工授精,但都以失败告终。后来,他们了解到第二代试管婴儿技术,在HRC专家的建议下,决定尝试这项技术。在治疗过程中,HRC专家通过单精子卵胞浆内注射技术,将单个精子直接注射到卵子内,实现了精准受精。经过精心的胚胎培养和移植,妻子成功怀孕。如今,他们的孩子已经两岁,活泼可爱。汤先生激动地说:“第二代试管婴儿技术给了我们这个家希望,让我们的生活变得完整。”
HRC案例三:高龄女性的三代技术奇迹

40岁的莎拉(化名)是一位职场女性,由于工作繁忙,一直推迟生育计划。当她决定要孩子时,却发现自己的生育之路充满坎坷。莎拉尝试了两次一代试管婴儿技术,都没有成功。HRC专家告诉她,随着年龄的增长,卵子质量下降,一代试管成功率较低,而且随着染色体异常的风险增加,流产风险也会显著上升,建议她选择第三代试管婴儿技术。莎拉听从了HRC专家的建议,采用第三代试管婴儿技术进行胚胎染色体筛查。经过努力,莎拉成功怀上了宝宝。她兴奋地说:“在我几乎要放弃的时候,第三代试管婴儿技术让我迎来了生命中的奇迹,真的非常感激。”

联系我们:400 111 1951
微信公众号:HRC FERTILITY官方公众号

微信视频号:HRC FERTILITY

推荐联系方式:
客服微信:hrc_service02
咨询电话:15501217090